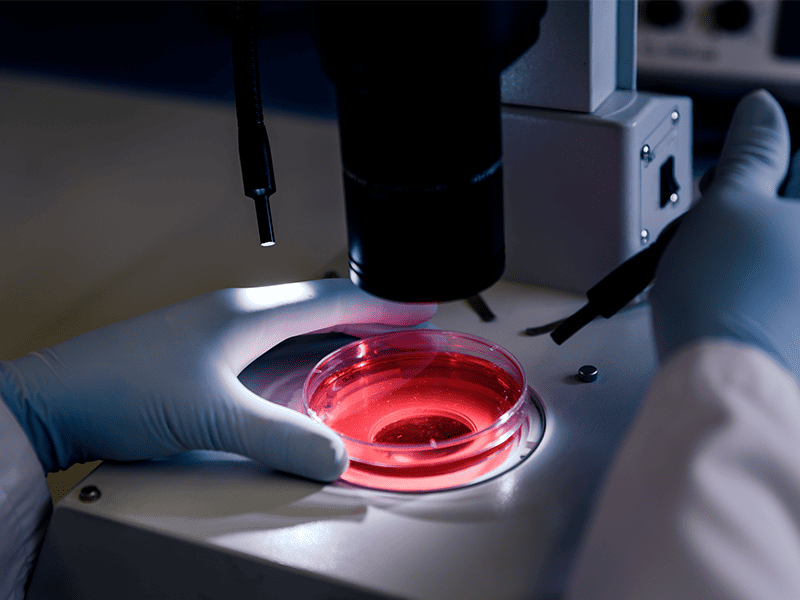
Миелодиспластический синдром-5

Миелодиспластический синдром (МДС) – это специфическое заболевание, связанное с нарушением кроветворения. Является предраковым состоянием, которое может привести к развитию лейкемии.
Патология проявляется в недостаточности нормально функционирующих стволовых клеток, в то время как количество незрелых клеток (бластов) может увеличиваться. Диагноз устанавливается по результатам лабораторных анализов.
80% пациентов с МДС заболеванием — это люди старше 60 лет. Заболевание развивается вследствие генетических мутаций, возникающих в процессе жизни, а не являющихся наследственными.
В институте онкологии Hadassah Medical Moscow уделяется особое внимание исследованию и лечению миелодиспластического синдрома (МДС). Под руководством опытного онколога, Утяшева И.А., была сформирована выдающаяся команда специалистов, целью которой является предоставление наивысшего уровня медицинской помощи пациентам с этим заболеванием. В нашей клинике применяются передовые методики диагностики и индивидуализированные методы лечения МДС, включая таргетную терапию и реабилитацию, ориентированные на улучшение качества жизни каждого пациента.

Врачи отделения
Уникальность лечения болезни в Хадассе:
Лечение миелодиспластического синдрома в Hadassah Medical Moscow отличается комплексным и индивидуализированным подходом. Наша клиника предоставляет следующие преимущества:
Каждый пациент, обратившийся в Hadassah Medical Moscow, может быть уверен в высоком уровне профессионализма специалистов и в индивидуальном подходе к своему заболеванию.
Причины и классификация миелодиспластического синдрома
Среди всех случаев заболевания МДС у 90% пациентов выявляется первичный (идиопатический) синдром. Однозначные причины данной патологии специалистами не установлены. Но врачи называют следующие факторы риска:
- воздействие радиации;
- курение;
- постоянное воздействие на организм пестицидов и органических растворителей;
- врожденные заболевания (например, нейрофиброматоз, анемия Фанкони, синдром Дауна).
Вторичный миелодиспластический синдром может возникнуть в любом возрасте. Основной причиной, приводящей к данной патологии, является химио или радиотерапия. При вторичном варианте МДС выше риск развития лейкоза.
Каждый вид МДС требует особого подхода к диагностике и лечению, который определяется особенностями клинического течения, генетическими изменениями и реакцией организма на терапию.

Симптомы и признаки болезни
Миелобластный синдром проявляется различными клиническими симптомами. Часто они бывают схожи с другими заболеваниями, что затрудняет раннюю диагностику.
Чаще всего пациенты могут испытывать следующие признаки:
- общая слабость;
- быстрая утомляемость;
- бледность кожи, вызванная анемией;
- повышенная склонность к инфекционным заболеваниям из-за недостатка нормально функционирующих белых кровяных тел;
- появление кровотечений и гематом, синяков из-за снижения уровня тромбоцитов в крови;
- наличие крови в моче или кале.
Следует отметить, что выраженность симптомов МДС может варьироваться от легких проявлений до тяжелых, и зависит от стадии заболевания, степени поражения костного мозга и наличия сопутствующих заболеваний.
При первых подозрениях на возможное развитие миелодиспластического синдрома, необходимо незамедлительно обратиться к специалисту для детального обследования и выявления возможных рисков.

Диагностика болезни
Для выявления миелодиспластического синдрома и определения его типа применяется комплексное клиническое обследование. Это позволяет не только точно диагностировать заболевание, но и определить оптимальные методы лечения для каждого конкретного случая.
Важность ранней диагностики миелодиспластического синдрома не может быть переоценена, поскольку своевременное начало лечения способствует более благоприятному течению болезни и улучшает прогноз для пациента.
Лечение миелодиспластического синдрома
Специалисты используют индивидуальный подход к терапии миелодиспластического синдрома. Выбор способа лечения будет зависеть от общего состояния здоровья пациента, наличия у него хронических заболеваний, разновидность и стадию миелодиспластического синдрома.
В онкогематологии используются следующие способы лечения МСД.

Прогноз
Успех лечения при миелодиспластическом синдроме зависит от множества факторов, таких как вид миелодиспластического синдрома, стадию его развития, возраст пациента и наличие у него сопутствующих заболеваний.
Интегрированный подход, включая современные методы диагностики, таргетную терапию и поддерживающие мероприятия, позволяет максимизировать эффективность лечения. Несмотря на серьезность диагноза, многие пациенты способны вести полноценный образ жизни, контролируя свое состояние с помощью регулярных медицинских консультаций и адаптированных планов лечения.
Подтверждение диагноза МДС не является приговором. С прогрессом медицинских технологий и появлением новых методов лечения прогноз и качество жизни пациентов с таким диагнозом постоянно улучшается.
Профилактика болезни
Профилактика миелодиспластического синдрома включает в себя ряд мер, направленных на минимизацию факторов риска. Хотя конкретные причины МДС до конца не установлены, существуют рекомендации, способствующие уменьшению вероятности развития этого заболевания.
- Избегание воздействия химических веществ. Особенно это касается профессиональных рисков для людей, работающих в химической промышленности или с агрохимикатами.
- Прекращение курения. Доказано, что никотин в несколько раз увеличивает риск риск развития злокачественных заболеваний..
- Регулярные медицинские осмотры. Своевременная диагностика потенциальных проблем с кровью или костным мозгом может способствовать раннему началу лечения и более благоприятному прогнозу.
- Здоровое питание. Поддержание здорового образа жизни и сбалансированного питания также играет роль в поддержании общего здоровья и укреплении иммунной системы.
- Информированность. Знание о миелодиспластическом синдроме и его симптомах способствует раннему обнаружению и лечению заболевания.

Заключение
Миелодиспластический синдром — это сложное заболевание, требующее тщательной диагностики и индивидуального подхода к лечению.
Современные методы лечения, адаптированные к индивидуальным особенностям каждого пациента, позволяют добиваться оптимальных результатов, облегчая симптомы заболевания и улучшая качество жизни.
В Hadassah Medical Moscow мы объединяем передовые научные исследования, международный опыт и инновационные технологии для обеспечения высококачественной медицинской помощи каждому пациенту.
В Hadassah Medical Moscow каждому пациенту гарантирован индивидуализированный подход, направленный на максимальную эффективность лечения.
Врачи Hadassah Medical Moscow тесно взаимодействуют с пациентами, обсуждая все доступные опции лечения и помогая принять обоснованное решение. Наша цель — обеспечить каждому пациенту наиболее эффективное и безопасное лечение, максимально учитывая индивидуальные особенности его организма и заболевания.
В Hadassah Medical Moscow мы стремимся оптимизировать результаты лечения, применяя индивидуализированные стратегии и мониторинг пациентов на каждом этапе терапии.

В Hadassah Medical Moscow мы предоставляем комплексную информацию и поддержку для пациентов и их семей, помогая навигировать через процесс диагностики и лечения, а также предоставляя рекомендации по профилактике.
Наши специалисты тесно сотрудничают с пациентами и их семьями, стремясь обеспечить всестороннюю поддержку на каждом этапе лечения.
Источники
- Fenaux P., Haase D. Myelodysplastic Syndromes: Diagnosis and Treatment. // Journal of Clinical Oncology. – 2019. – Т. 37. – №12. – С. 1001–1014.
- Greenberg P.L., Stone R.M. The Biology and Treatment of Myelodysplastic Syndromes. // Blood Advances. – 2020. – Т. 4. – №9. – С. 2172–2181.
- Garcia-Manero G. Myelodysplastic Syndromes: 2022 Update on Diagnosis, Risk Stratification and Management. // American Journal of Hematology. – 2022. – Т. 97. – №1. – С. 42–63.
- Arber D.A., Orazi A., Hasserjian R. The 2016 revision to the World Health Organization classification of myeloid neoplasms and acute leukemia. // Blood. – 2016. – Т. 127. – №20. – С. 2391–2405.
- Malcovati L., Hellstrom-Lindberg E., Bowen D. Diagnosis and treatment of primary myelodysplastic syndromes in adults: recommendations from the European LeukemiaNet. // Blood. – 2013. – Т. 122. – №17. – С. 2943–2964.
Цены на услуги онколога
| Прием (осмотр, консультация) врача-онколога первичный B01.027.001 | B01.027.001 10 000 ₽ |
| Прием (осмотр, консультация) врача-онколога повторный B01.027.002 | B01.027.002 8 500 ₽ |
| Прием (осмотр, консультация) врача-онколога, кандидата медицинских наук, первичный B01.027.001.001 | B01.027.001.001 13 000 ₽ |
| Прием (осмотр, консультация) врача-онколога, кандидата медицинских наук, повторный B01.027.002.001 | B01.027.002.001 11 000 ₽ |
| Прием (осмотр, консультация) врача-онколога, доктора медицинских наук, первичный B01.027.001.002 | B01.027.001.002 16 000 ₽ |
| Прием (осмотр, консультация) врача-онколога, доктора медицинских наук, повторный B01.027.002.002 | B01.027.002.002 14 000 ₽ |
| Прием (осмотр, консультация) врача-онколога, специалиста института онкологии (консультация с составлением плана лечения), первичный B01.027.001.045 | B01.027.001.045 13 000 ₽ |
| Прием (осмотр, консультация) врача-онколога, специалиста института онкологии (консультация с составлением плана лечения), повторный B01.027.002.015 | B01.027.002.015 11 000 ₽ |
| Прием (осмотр, консультация) врача-онколога, профессора института онкологии (консультация с составлением плана лечения), первичный B01.027.001.046 | B01.027.001.046 16 000 ₽ |
| Прием (осмотр, консультация) врача-онколога, профессора института онкологии (консультация с составлением плана лечения), повторный B01.027.002.016 | B01.027.002.016 14 000 ₽ |
| Прием (осмотр консультация) иностранного врача-онколога B01.027.001.150 | B01.027.001.150 60 000 ₽ |
| Прием (осмотр, консультация) врача-онколога, директора института онкологии B01.027.001.076 | B01.027.001.076 21 000 ₽ |
| Удаленная консультация врача-онколога B01.027.001.021 | B01.027.001.021 8 500 ₽ |
| Удаленная консультация врача-онколога, кандидата медицинских наук B01.027.001.023 | B01.027.001.023 11 000 ₽ |
| Удаленная консультация врача-онколога, специалиста института онкологии (консультация с составлением плана лечения) B01.027.001.105 | B01.027.001.105 9 600 ₽ |
| Удаленная консультация врача-онколога, профессора института онкологии (консультация с составлением плана лечения) B01.027.001.103 | B01.027.001.103 14 000 ₽ |
| Удаленная консультация врача-онколога, главного специалиста по онкологии B01.027.001.106 | B01.027.001.106 11 000 ₽ |
| Удаленная консультация врача-онколога, директора института онкологии B01.027.001.077 | B01.027.001.077 21 000 ₽ |
| Онкологический консилиум B01.027.001.051 | B01.027.001.051 27 800 ₽ |
| Междисциплинарный консилиум с участием иностранных специалистов B01.027.001.052 | B01.027.001.052 115 500 ₽ |
| Проведение федерального консилиума B01.027.001.067 | B01.027.001.067 22 900 ₽ |
| Удаленная консультация израильского врача-онколога, заведующего отделением B01.027.001.100 | B01.027.001.100 150 000 ₽ |
| Удаленная консультация израильского врача-онколога B01.027.001.107 | B01.027.001.107 75 000 ₽ |
| Удаленная консультация израильского врача-онколога, ведущего специалиста B01.027.001.101 | B01.027.001.101 100 000 ₽ |
| Удаленная консультация израильского врача-онколога, профессора B01.027.001.102 | B01.027.001.102 200 000 ₽ |
| Тонкоигольная аспирационная биопсия щитовидной или паращитовидной железы под контролем ультразвукового исследования A11.22.001.001.001 | A11.22.001.001.001 8 000 ₽ |
| Спинномозговая пункция A11.23.001 | A11.23.001 16 600 ₽ |
| Уход за венозным портом (промывка порта) A14.12.002.001 | A14.12.002.001 3 900 ₽ |
| Уход за венозным катетером системы PICC-line A14.12.001.005 | A14.12.001.005 2 900 ₽ |
| Наложение малой асептической повязки A15.01.001.055 | A15.01.001.055 1 100 ₽ |
| Наложение большой асептической повязки A15.01.001.056 | A15.01.001.056 2 000 ₽ |
| Трепан-биопсия костного мозга крыла подвздошной кости A11.03.001.001.001 | A11.03.001.001.001 25 500 ₽ |
| Аспирационная биопсия костного мозга A11.05.002.004 | A11.05.002.004 12 800 ₽ |
| Гемоэксфузия A18.05.009.001 | A18.05.009.001 6 500 ₽ |
| Установка радиометок под контролем компьютерной томографии (без стоимости радиометок) 1-3 шт. A07.30.021.001 | A07.30.021.001 17 900 ₽ |
| Трепанобиопсия костей под контролем компьютерной томографии A11.03.001.003.002 | A11.03.001.003.002 48 600 ₽ |
| Диагностическая пункция жидкостных скоплений/кистозных образований (любой локализации) с забором материала для цитологического исследования A11.30.024.001.002 | A11.30.024.001.002 15 400 ₽ |
| Дренирование плевральной полости A16.09.004 | A16.09.004 12 800 ₽ |
| Резекция нижней челюсти A16.03.081 | A16.03.081 840 000 ₽ |
| Резекция ротоглотки комбинированная A16.07.081.001 | A16.07.081.001 1890 000 ₽ |
| Пластика дефекта полости рта, глотки перемещенным лоскутом A16.30.075.008 | A16.30.075.008 1260 000 ₽ |
| Установка пункционной трахеостомы под видеоэндоскопическим контролем A16.08.003.001 | A16.08.003.001 472 500 ₽ |
| Лимфаденэктомия шейная расширенная A16.06.006.002 | A16.06.006.002 840 000 ₽ |
| Лечение с использованием препарата Карбоплатин-Тева 150 мг (1 фл.) A11.12.003.001.126 | A11.12.003.001.126 2 000 ₽ |
| Лечение с использованием препарата Карбоплатин-Тева 450 мг (1 фл.) A11.12.003.001.127 | A11.12.003.001.127 4 600 ₽ |
Другие заболевания, которые мы лечим
- Аденокарцинома желудка
- Аденокарцинома легких
- Аденокарцинома матки
- Аденокарцинома молочной железы
- Аденокарцинома простаты
- Аденокарцинома толстой кишки
- Ангиосаркома
- Апокринный рак
- Базалиома
- Базальноклеточный рак кожи
- В-клеточная лимфома
- Воспалительный рак молочной железы
- Гастроинтестинальные стромальные опухоли
- Гемобластоз
- Гинекомастия
- Гипернефроидная опухоль
- Глиобластома головного мозга
- Дерматофибросаркома
- Десмоидные фибромы
- Жировой рак
- Каверномы
- Канцероматоз брюшины
- Карциноид
- Карциноидная опухоль
- Кератома (себорейный кератоз)
- Колоректальный рак
- Краниофарингиома
- Лейомиосаркома
- Лимфома
- Лимфома Беркитта
- Лимфома кожи
- Лимфома Ходжкина
- Лимфосаркома
- Липосаркома
- Медуллобластома
- Медуллярный рак
- Меланома
- Меланома глаза
- Мелкоклеточный рак легких
- Метастазы
- Метастазы в брюшину
- Метастазы в печени
- Метастазы рака в печень
- Метастатическое поражение брюшины
- Миелодиспластический синдром
- Миелолейкоз
- Множественная миелома
- Нейроэндокринные опухоли
- Нефробластома
- Неходжкинские лимфомы
- Опухоли забрюшинного пространства
- Опухоли мягких тканей
- Опухоли средостения
- Остеобластокластома
- Остеома
- Остеосаркома
- Острый лимфолейкоз
- Острый миелобластный лейкоз
- Папиллярный инвазивный рак
- Первичный рак печени
- Перитонеальный карциноматоз
- Периферический рак легкого
- Плоскоклеточный рак кожи
- Плоскоклеточный рак легких
- Плоскоклеточный рак шейки матки
- Рабдомиосаркома
- Рак анального канала
- Рак бронхов
- Рак влагалища
- Рак внепеченочных желчных протоков
- Рак вульвы
- Рак глаза
- Рак гортани
- Рак губы
- Рак двенадцатиперстной кишки
- Рак десны
- Рак желудка
- Рак желчного пузыря
- Рак кожи
- Рак легкого
- Рак лимфоузлов
- Рак матки
- Рак маточной трубы
- Рак миндалин
- Рак мозга
- Рак молочной железы различной локализации
- Рак молочной железы у мужчин
- Рак мочевого пузыря
- Рак мочевого пузыря
- Рак мочеточников
- Рак надпочечника
- Рак носоглотки
- Рак ободочной кишки
- Рак паращитовидной железы
- Рак Педжета
- Рак печени
- Рак пищевода
- Рак плевры
- Рак поджелудочной железы
- Рак полового члена
- Рак полости рта
- Рак почки
- Рак предстательной железы
- Рак прямой кишки
- Рак ротовой полости
- Рак ротоглотки
- Рак сердца
- Рак слюнных желез
- Рак слюнных желез
- Рак тимуса
- Рак толстой кишки
- Рак трахеи
- Рак фатерова соска
- Рак шейки матки
- Рак щитовидной железы
- Рак эндометрия
- Рак языка
- Рак яичка
- Рак яичников
- Распространение рака на брюшину
- Саркоидоз легких
- Саркома
- Саркома Капоши
- Саркома легкого
- Саркома матки
- Саркома молочной железы
- Саркома мягких тканей
- Саркома Юинга
- Секреторный рак
- Синовиальная саркома
- Тимома
- Трофобластическая болезнь
- Фибросаркома
- Хондрома
- Хондросаркома
- Хордома
- Хронические миелопролиферативные заболевания
- Хронический лимфолейкоз



































